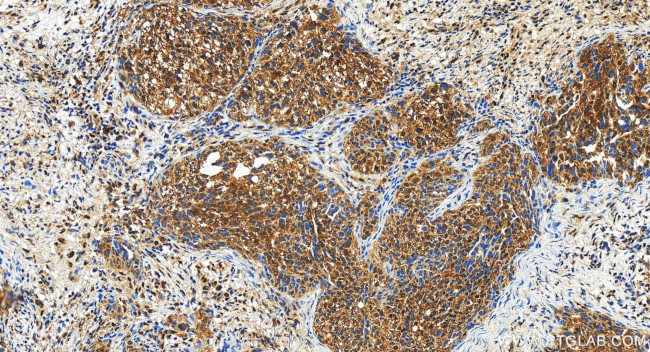
MAGI3 Antibody in Immunohistochemistry (Paraffin) (IHC (P))

Search
Proteintech
MAGI3 Polyclonal Antibody
{{$productOrderCtrl.translations['antibody.pdp.commerceCard.promotion.promotions']}}
{{$productOrderCtrl.translations['antibody.pdp.commerceCard.promotion.viewpromo']}}
{{$productOrderCtrl.translations['antibody.pdp.commerceCard.promotion.promocode']}}: {{promo.promoCode}} {{promo.promoTitle}} {{promo.promoDescription}}. {{$productOrderCtrl.translations['antibody.pdp.commerceCard.promotion.learnmore']}}
产品信息
22615-1-AP
种属反应
宿主/亚型
分类
类型
抗原
偶联物
形式
浓度
规格
纯化类型
保存液
内含物
保存条件
运输条件
产品详细信息
Immunogen sequence: LPDDSEDPVV DIVAATPVIN GQSLTKGETC MNPQDFKPGA MVLEQNGKSG HTLTGDGLNG PSDASEQRVS MASSGSSQPE LVTIPLIKGP KGFGFAIADS PTGQKVKMIL DSQWCQGLQK GDIIKEIYHQ NVQNLTHLQV VEVLKQFPVG ADVPLLILRG GPPSPTKTAK MKTDKKENAG SLEAINEPIP QPMPFPPSII RSGSPKLDPS EVYLKSKTLY EDKPPNTKDL DVFLRKQESG FGFRVLGGDG PDQSIYIGAI IPLGAAEKDG RLRAADELMC ID
靶标信息
Membrane-associated guanylate kinase with inverted orientation (MAGI3) is a novel, 130 kDa guanylate kinase which is part of a family of multi-PDZ domain containing guanylate kinases. These guanylate kinases are localized to epithelial cell tight junctions. MAGI3 and PTEN/MMAC cooperate to modulate the kinase activity of AKT/protein kinase B (PKB). MAGI3 positions the PTEN/MMAC phosphatase to specific subcellular locations that are involved with the regulation of cell proliferation and survival. MAGI3, as well as other proteins in this family, are made up of an N-terminal guanylate kinase domain, followed by a WW domain, named for two conserved tryptophan residues and first identified as two repeats in mouse YAP65, which is them followed by 5 PDZ domains.
仅用于科研。不用于诊断过程。未经明确授权不得转售。
篇参考文献 (0)
生物信息学
蛋白别名: GKWW domain; MAGI-3; Membrane-associated guanylate kinase inverted 3; Membrane-associated guanylate kinase, WW and PDZ domain-containing protein 3; membrane-associated guanylate kinase-related (MAGI-3); membrane-associated guanylate kinase-related 3; PDZ 4-5; RP4-730K3.1; scaffolding protein SLIPR; Scaffolding-like protein; unnamed protein product
基因别名: 4732496O19Rik; 6530407C02Rik; AA407180; AI120132; dJ730K3.2; KIAA1634; MAGI-3; MAGI3; mKIAA1634; Slipr
UniProt ID: (Human) Q5TCQ9, (Rat) Q9JK71, (Mouse) Q9EQJ9
Entrez Gene ID: (Human) 260425, (Rat) 245903, (Mouse) 99470